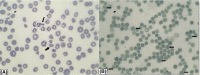

Endocarditis-induced thrombotic thrombocytopenic purpura mimicking preeclampsia: A case report
- PMID: 34257975
- PMCID: PMC8259797
- DOI: 10.1002/ccr3.4364
Endocarditis-induced thrombotic thrombocytopenic purpura mimicking preeclampsia: A case report
Abstract
TTP, Preeclampsia have similar manifestations in pregnancy. Establishing the right diagnosis is essential as the treatment is different. Endocarditis-induced TTP should be suspected when neurological symptoms, thrombocytopenia are present.
Keywords: case report; infection; preeclampsia; pregnancy; thrombotic thrombocytopenic purpura.
© 2021 The Authors. Clinical Case Reports published by John Wiley & Sons Ltd.
Conflict of interest statement
None declared.
Figures

References
-
- Walker BR, Colledge NR, Ralston S, Penman ID, Britton R. Davidson's Principles and Practice of Medicine, 22nd edn. Edinburgh, NY: Churchill Livingstone/Elsevier; 2014.
-
- Tsai HM. von Willebrand factor, shear stress, and ADAMTS13 in hemostasis and thrombosis. ASAIO J. 2012;58(2):163‐169. - PubMed
-
- Selleng K, Warkentin TE, Greinacher A, et al. Very severe thrombocytopenia and fragmentation hemolysis mimicking thrombotic thrombocytopenic purpura associated with a giant intracardiac vegetation infected with staphylococcus epidermidis: role of monocyte procoagulant activity induced by bacterial supernatant. Am J Hematol. 2007;82(8):766‐771. - PubMed
-
- Scully M, Hunt BJ, Benjamin S, et al. Guidelines on the diagnosis and management of thrombotic thrombocytopenic purpura and other thrombotic microangiopathies. Br J Haematol. 2012;158(3):323‐335. - PubMed
Publication types
LinkOut - more resources
Full Text Sources

